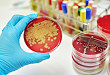

-

-
2017.12.14 慢性肾脏病:肾脏替代治疗及死亡率
本部分综述了慢性肾病的肾脏替代治疗和死亡率方面的流行病学数据。
-

-
2017.12.14 慢性肾脏病:发病机制及病理生理过程
慢性肾脏病已经成为全球公共卫生问题,理解其诊断和治疗,先要了解其病理生理机制。
-

-
2017.12.07 肾结石复发的有效预防和治疗方式
来自芝加哥大学肾脏内科的Anna L. Zisman教授为此在2017年10月的CJASN杂志上撰写综述,详细阐述了预防和治疗各种不同类型结石复发的方法。
-
-
2017.11.30 他汀类或是控制金葡菌感染的新帮手
他汀类药物除了可以调节血脂、抗动脉粥样硬化、保护血管外,其多效性已得到证实。动脉粥样硬化和菌血症之间具有相似的病理生理过程,他汀类药物可能对治疗菌血症有效。
-

-
2017.11.21 前列地尔注射液,静脉滴注是超说明书用药?
选择正确的给药途径。
-

-
2017.11.21 女性尿路感染,指南教你如何用药
指南结合实践。
-

-
2017.11.09 补充维生素 D 选 D2 还是 D3?有差吗?
选药也得有诀窍!
-

-
2017.10.25 经验性抗感染有效,药敏提示耐药,抗菌药物换不换?
在临床工作中,我们有时会遇到下面这样的情况:在药敏试验结果出来之前,我们首先进行了经验性抗感染治疗,且临床观察显示治疗是有效的。可是,后来的药敏试验结果却显...
-

-
2017.10.23 亚洲地区 CKD-MBD 现状及管理
来自于日本东开大学的Masafumi Fukagawa教授等总结了关于亚洲地区的CKD-MBD现状及管理,发表于2017年7月的AJKD杂志上。
-

-
2017.10.23 病毒相关性肾小球肾炎概述
病毒相关性肾小球肾炎意味着病毒复制活跃与肾小球肾炎的发生有直接的致病性关系。其病理生理机制非常多样,不同病毒有不同的致病方式。本文将帮助您理清其中的头绪。
- os
